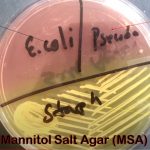
MSA: Introduction, Composition, Preparation, Test Procedure, Colony Characteristics and Keynotes

Tag: Test Procedure ( specimen/organism inoculation)
MSA: Introduction, Composition, Preparation, Test Procedure, Colony Characteristics and Keynotes
Introduction of MSA MSA stands for Mannitol Salt Agar and...
Introduction of MSA MSA stands for Mannitol Salt Agar and...
MacConkey Medium: Introduction, Principle, Composition, Preparation, Procedure, Colony Morphology and Uses
 Introduction of MacConkey Medium MacConkey agar(MAC) or MacConkey Medium uses for...
Introduction of MacConkey Medium MacConkey agar(MAC) or MacConkey Medium uses for...
PDA: Introduction, Principle, Composition, Test Procedure, Colony Characteristics and Uses
 Introduction of PDA PDA stands for Potato Dextrose Agar and...
Introduction of PDA PDA stands for Potato Dextrose Agar and...
